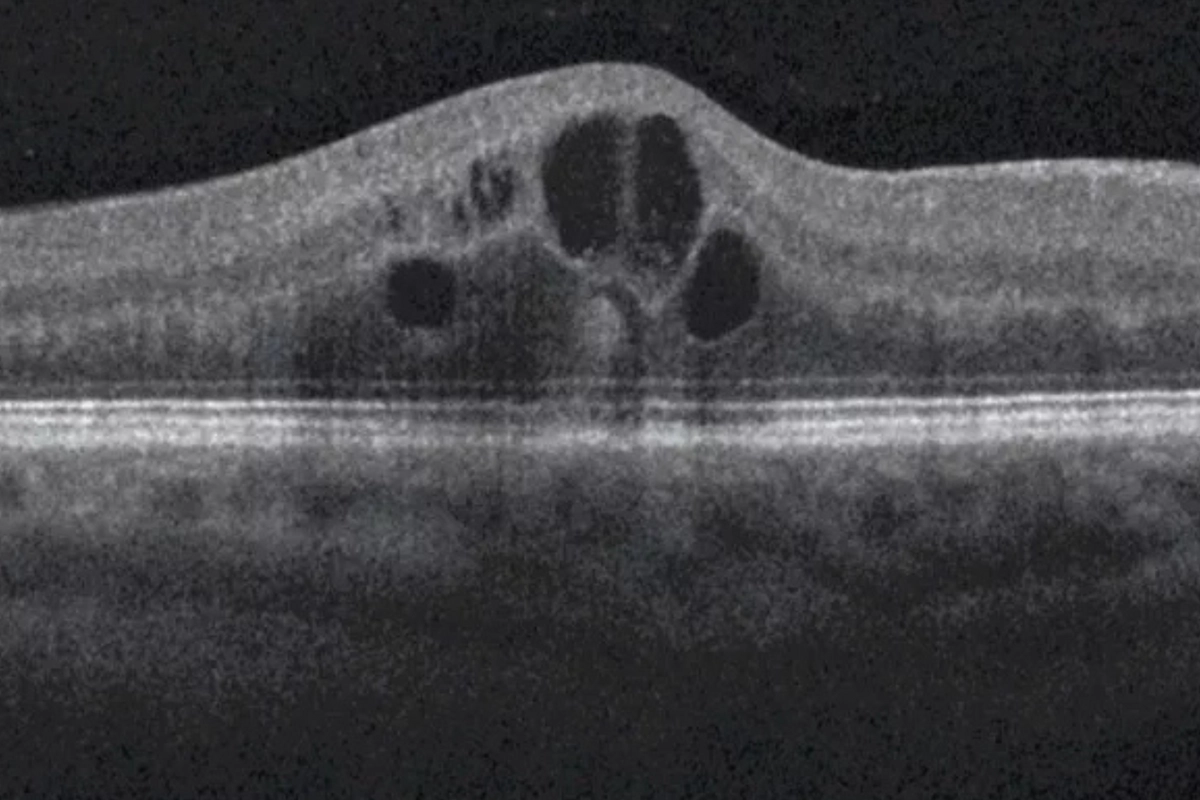
OCT scan showing diabetic macular edema — fluid accumulation in the macula at Stratus Eye in Suwanee, GA

Dilation allows Dr. Tran to examine the full retina directly — evaluating blood vessel integrity, identifying microaneurysms, hemorrhages, and neovascularization, and assessing the optic nerve in the same visit. No referral needed, no separate appointment. Every diabetic patient receives a dilated exam at every comprehensive visit.

The gold standard for detecting diabetic macular edema. OCT produces a precise, cross-sectional map of your macula — measuring retinal thickness, identifying fluid accumulation, and detecting structural changes that are completely invisible during a standard exam. It's how we catch DME early, before it causes permanent central vision loss.

Diabetic retinopathy doesn't exist in isolation. Blood sugar control, blood pressure, cholesterol, and medication adherence all directly influence how quickly the disease progresses. At every visit, Dr. Tran reviews your systemic risk factors alongside your retinal findings — and communicates with your primary care physician or endocrinologist when the clinical picture warrants it.

Advanced diabetic retinopathy carries a risk of neovascular glaucoma — one of the most aggressive forms of glaucoma, caused by abnormal blood vessels invading the eye's drainage angle. Intraocular pressure is measured at every visit for diabetic patients. Catching elevated pressure early is the difference between a manageable finding and a vision-threatening emergency.


Diabetic retinopathy is damage to the blood vessels of the retina caused by chronically elevated blood sugar. Over time, those vessels weaken, leak fluid, and can close off entirely — depriving the retina of oxygen and triggering the growth of abnormal new blood vessels. It is the leading cause of preventable blindness in working-age adults in the United States.

There are four main stages. Mild NPDR is the earliest, characterized by small microaneurysms in the retinal vessels. Moderate to severe NPDR involves more widespread vessel damage and blockage. Proliferative diabetic retinopathy (PDR) is the most advanced stage, marked by the growth of fragile new blood vessels that bleed easily and can cause retinal detachment. Diabetic macular edema can occur at any stage and is the most common cause of vision loss in diabetic patients.

Diabetic macular edema occurs when fluid leaks from damaged retinal blood vessels into the macula — the central part of the retina responsible for sharp, detailed vision. The macula swells, causing blurry or distorted central vision. DME can develop at any stage of diabetic retinopathy and requires prompt evaluation and coordinated care with a retina specialist.

Yes — it is the leading cause of preventable blindness in working-age adults in the United States. The critical word is preventable. When caught early and monitored appropriately, the risk of severe vision loss is dramatically reduced. The danger is that most patients have no symptoms until the disease is already advanced.

Neovascular glaucoma is a severe complication of advanced diabetic retinopathy. When abnormal blood vessels grow into the eye's drainage angle, they block fluid outflow and cause a rapid, dangerous rise in intraocular pressure. It is one of the most aggressive and difficult-to-treat forms of glaucoma. This is why intraocular pressure is measured at every diabetic eye exam at Stratus Eye — not just when symptoms appear.

The American Academy of Ophthalmology recommends that all Type 1 diabetics have a comprehensive dilated eye exam within 5 years of diagnosis, and all Type 2 diabetics at the time of diagnosis. After that, the frequency depends on your stage of disease. Mild NPDR typically warrants annual exams. Moderate to severe NPDR requires follow-up every 3–6 months. Any new visual symptoms should be evaluated immediately.

Early diabetic retinopathy can partially stabilize or improve with better blood sugar control, blood pressure management, and lifestyle changes. However, structural damage that has already occurred cannot be fully reversed. This is why early detection matters so much — the earlier the disease is identified, the more of your vision there is to protect.

Not always — and that's the point of monitoring. Many patients with early and intermediate NPDR never progress to vision-threatening disease, particularly with good systemic control and regular eye exams. The patients who lose vision are most often those who had no symptoms, assumed everything was fine, and skipped their annual exam.

Treatment depends on the stage. Early NPDR is managed with monitoring and systemic risk factor control. Diabetic macular edema and PDR are treated by retina specialists with anti-VEGF injections, laser photocoagulation, or vitreoretinal surgery when needed. At Stratus Eye, Dr. Tran evaluates and monitors your disease and coordinates your referral directly when intervention is required.

Yes — this is exactly the patient who most needs a dilated exam. Normal vision does not mean healthy retinas. Significant diabetic retinopathy can be present and actively progressing with no symptoms whatsoever. The exam is not to check your glasses prescription — it is to evaluate your retinal blood vessels directly, which cannot be done any other way.

Yes. High blood pressure accelerates retinal blood vessel damage independently of blood sugar levels. Patients with both poorly controlled diabetes and hypertension are at significantly higher risk of rapid progression to vision-threatening disease. Managing both conditions together is essential — and Dr. Tran reviews your systemic risk factors at every visit.

Intravitreal injections and laser photocoagulation for advanced diabetic retinopathy are performed by retina specialists. At Stratus Eye, Dr. Tran provides comprehensive evaluation, monitoring, and risk factor management — and coordinates your care directly with a trusted retina specialist when intervention is needed. You remain our patient throughout.
Stratus Eye is proud to serve diabetic patients from across the North Atlanta region. Whether you're coming from Suwanee, Johns Creek, Duluth, Alpharetta, Cumming, Buford, Sugar Hill, Gainesville, or Lawrenceville, Dr. Tran provides comprehensive diabetic retinopathy evaluations and ongoing monitoring — with the clinical experience and diagnostic technology to detect changes before they affect your vision. If you have diabetes and haven't had a dilated eye exam in the past year, this is the visit that matters.
